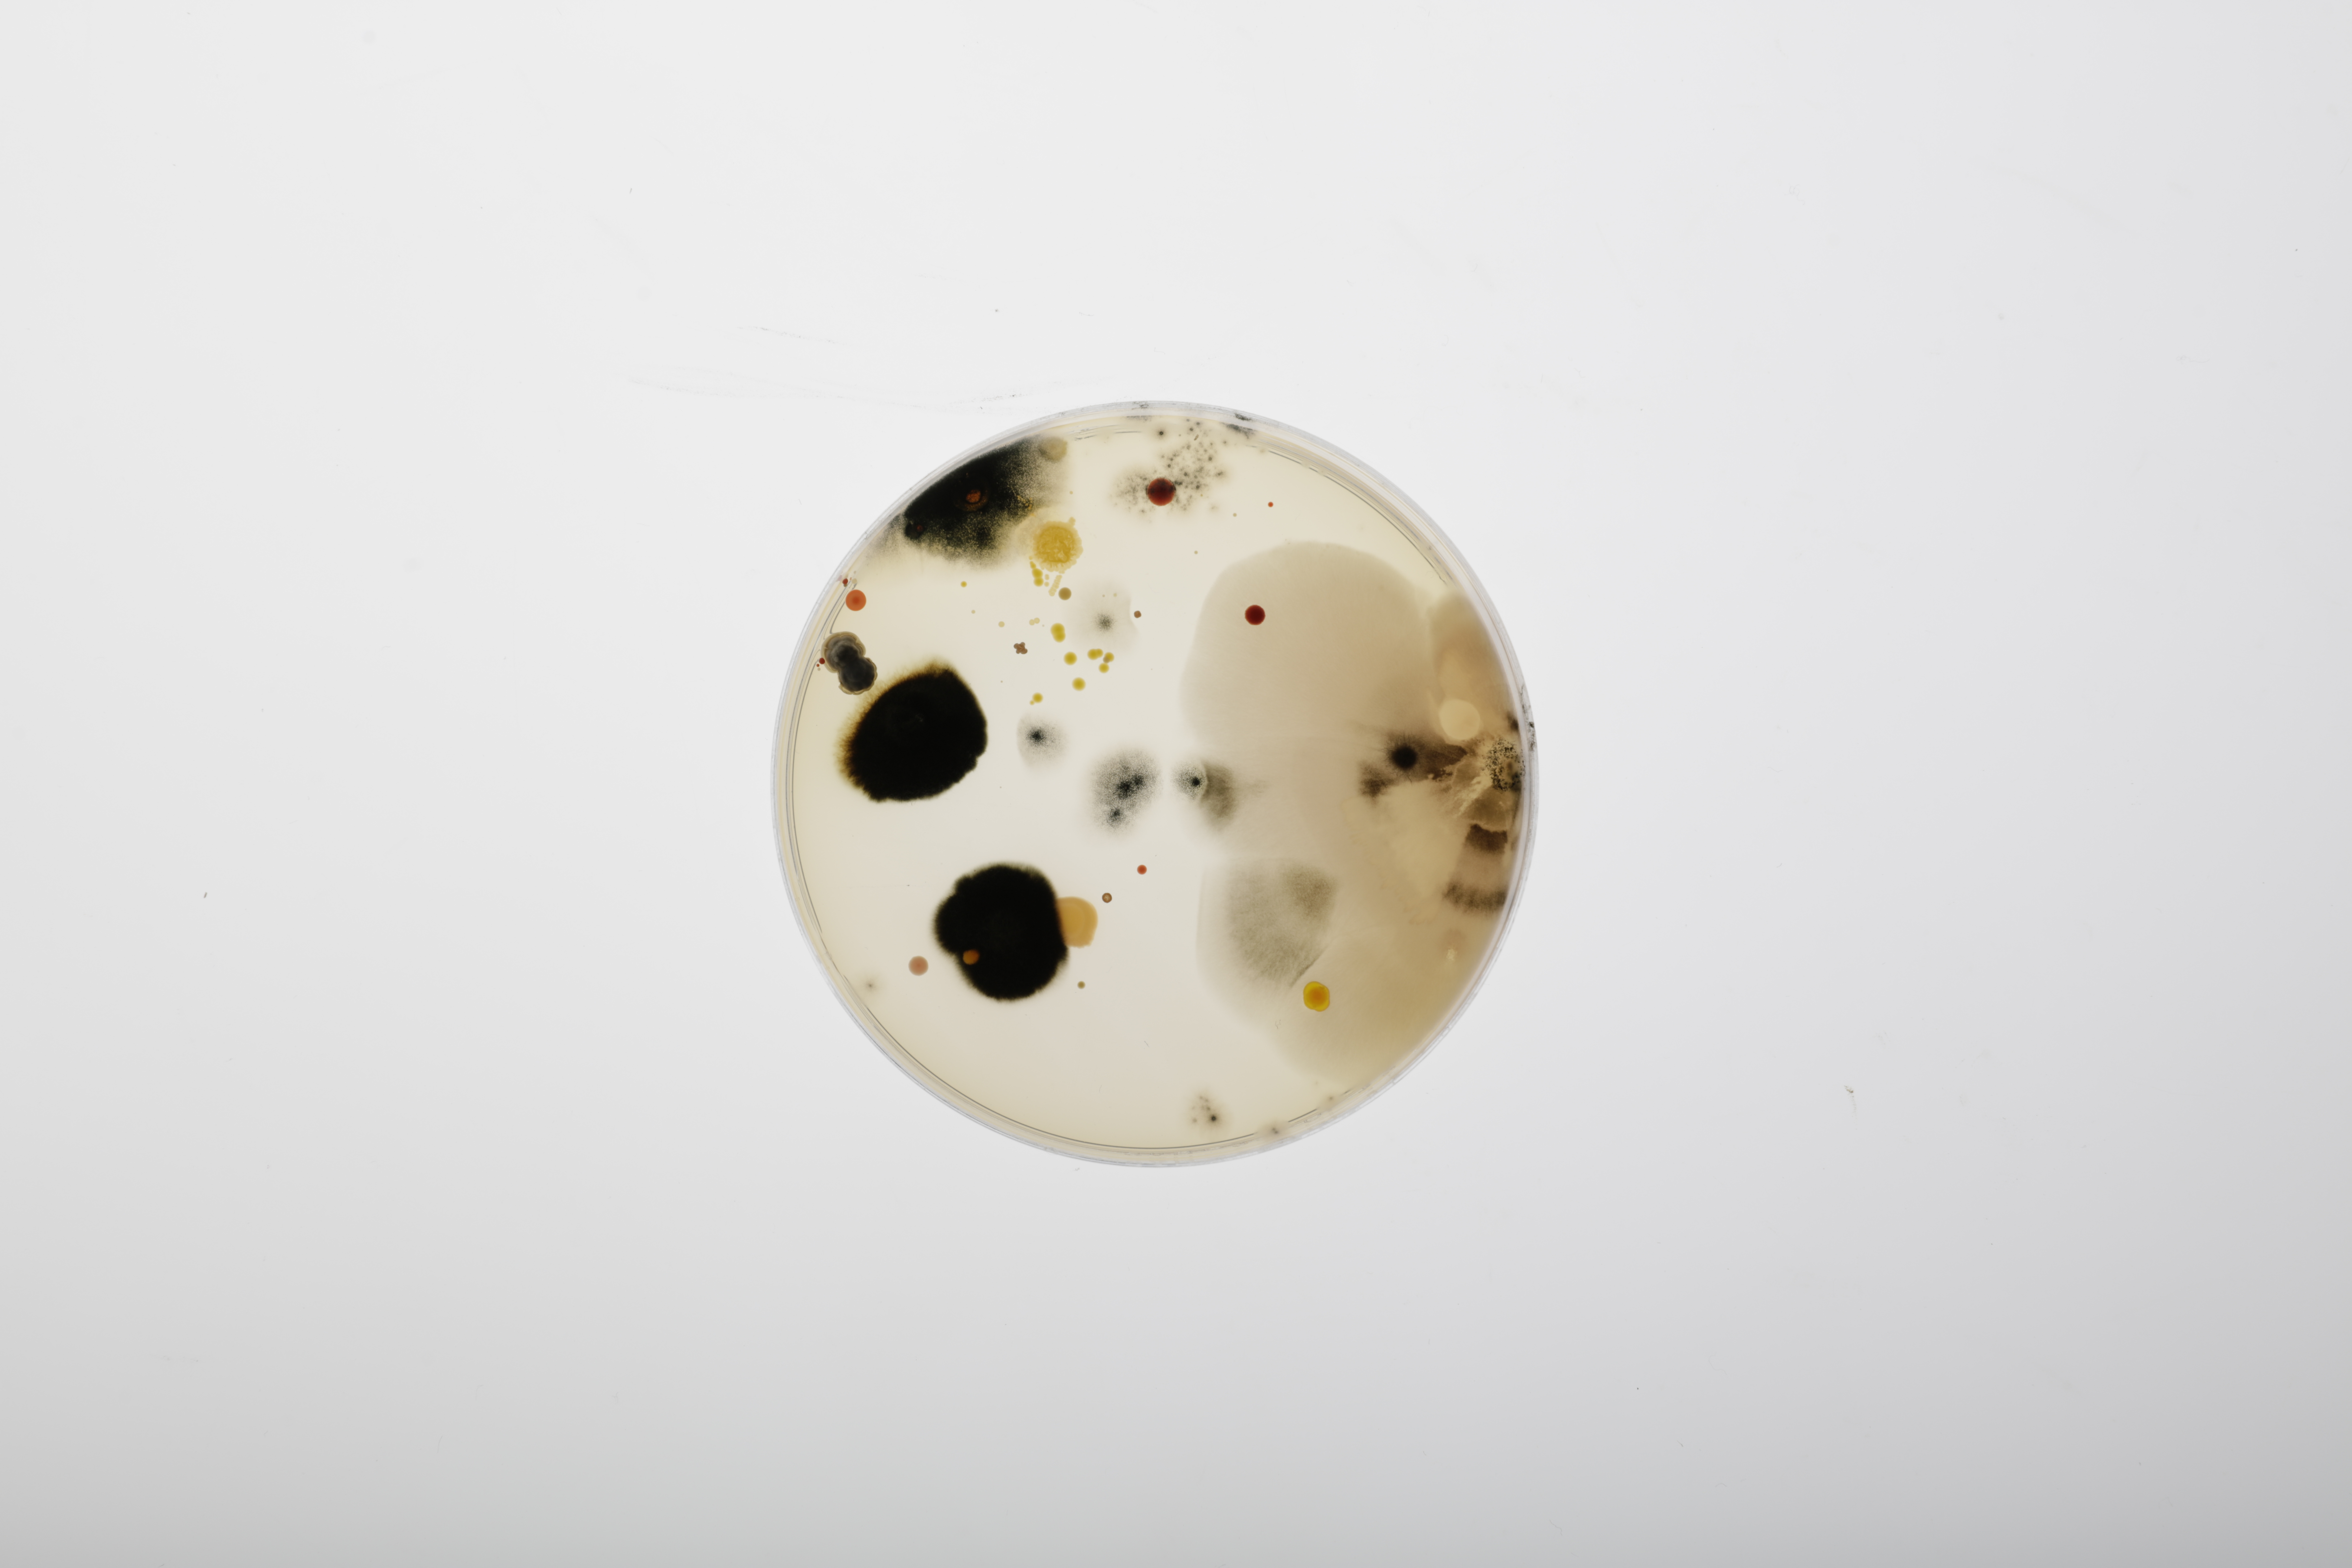
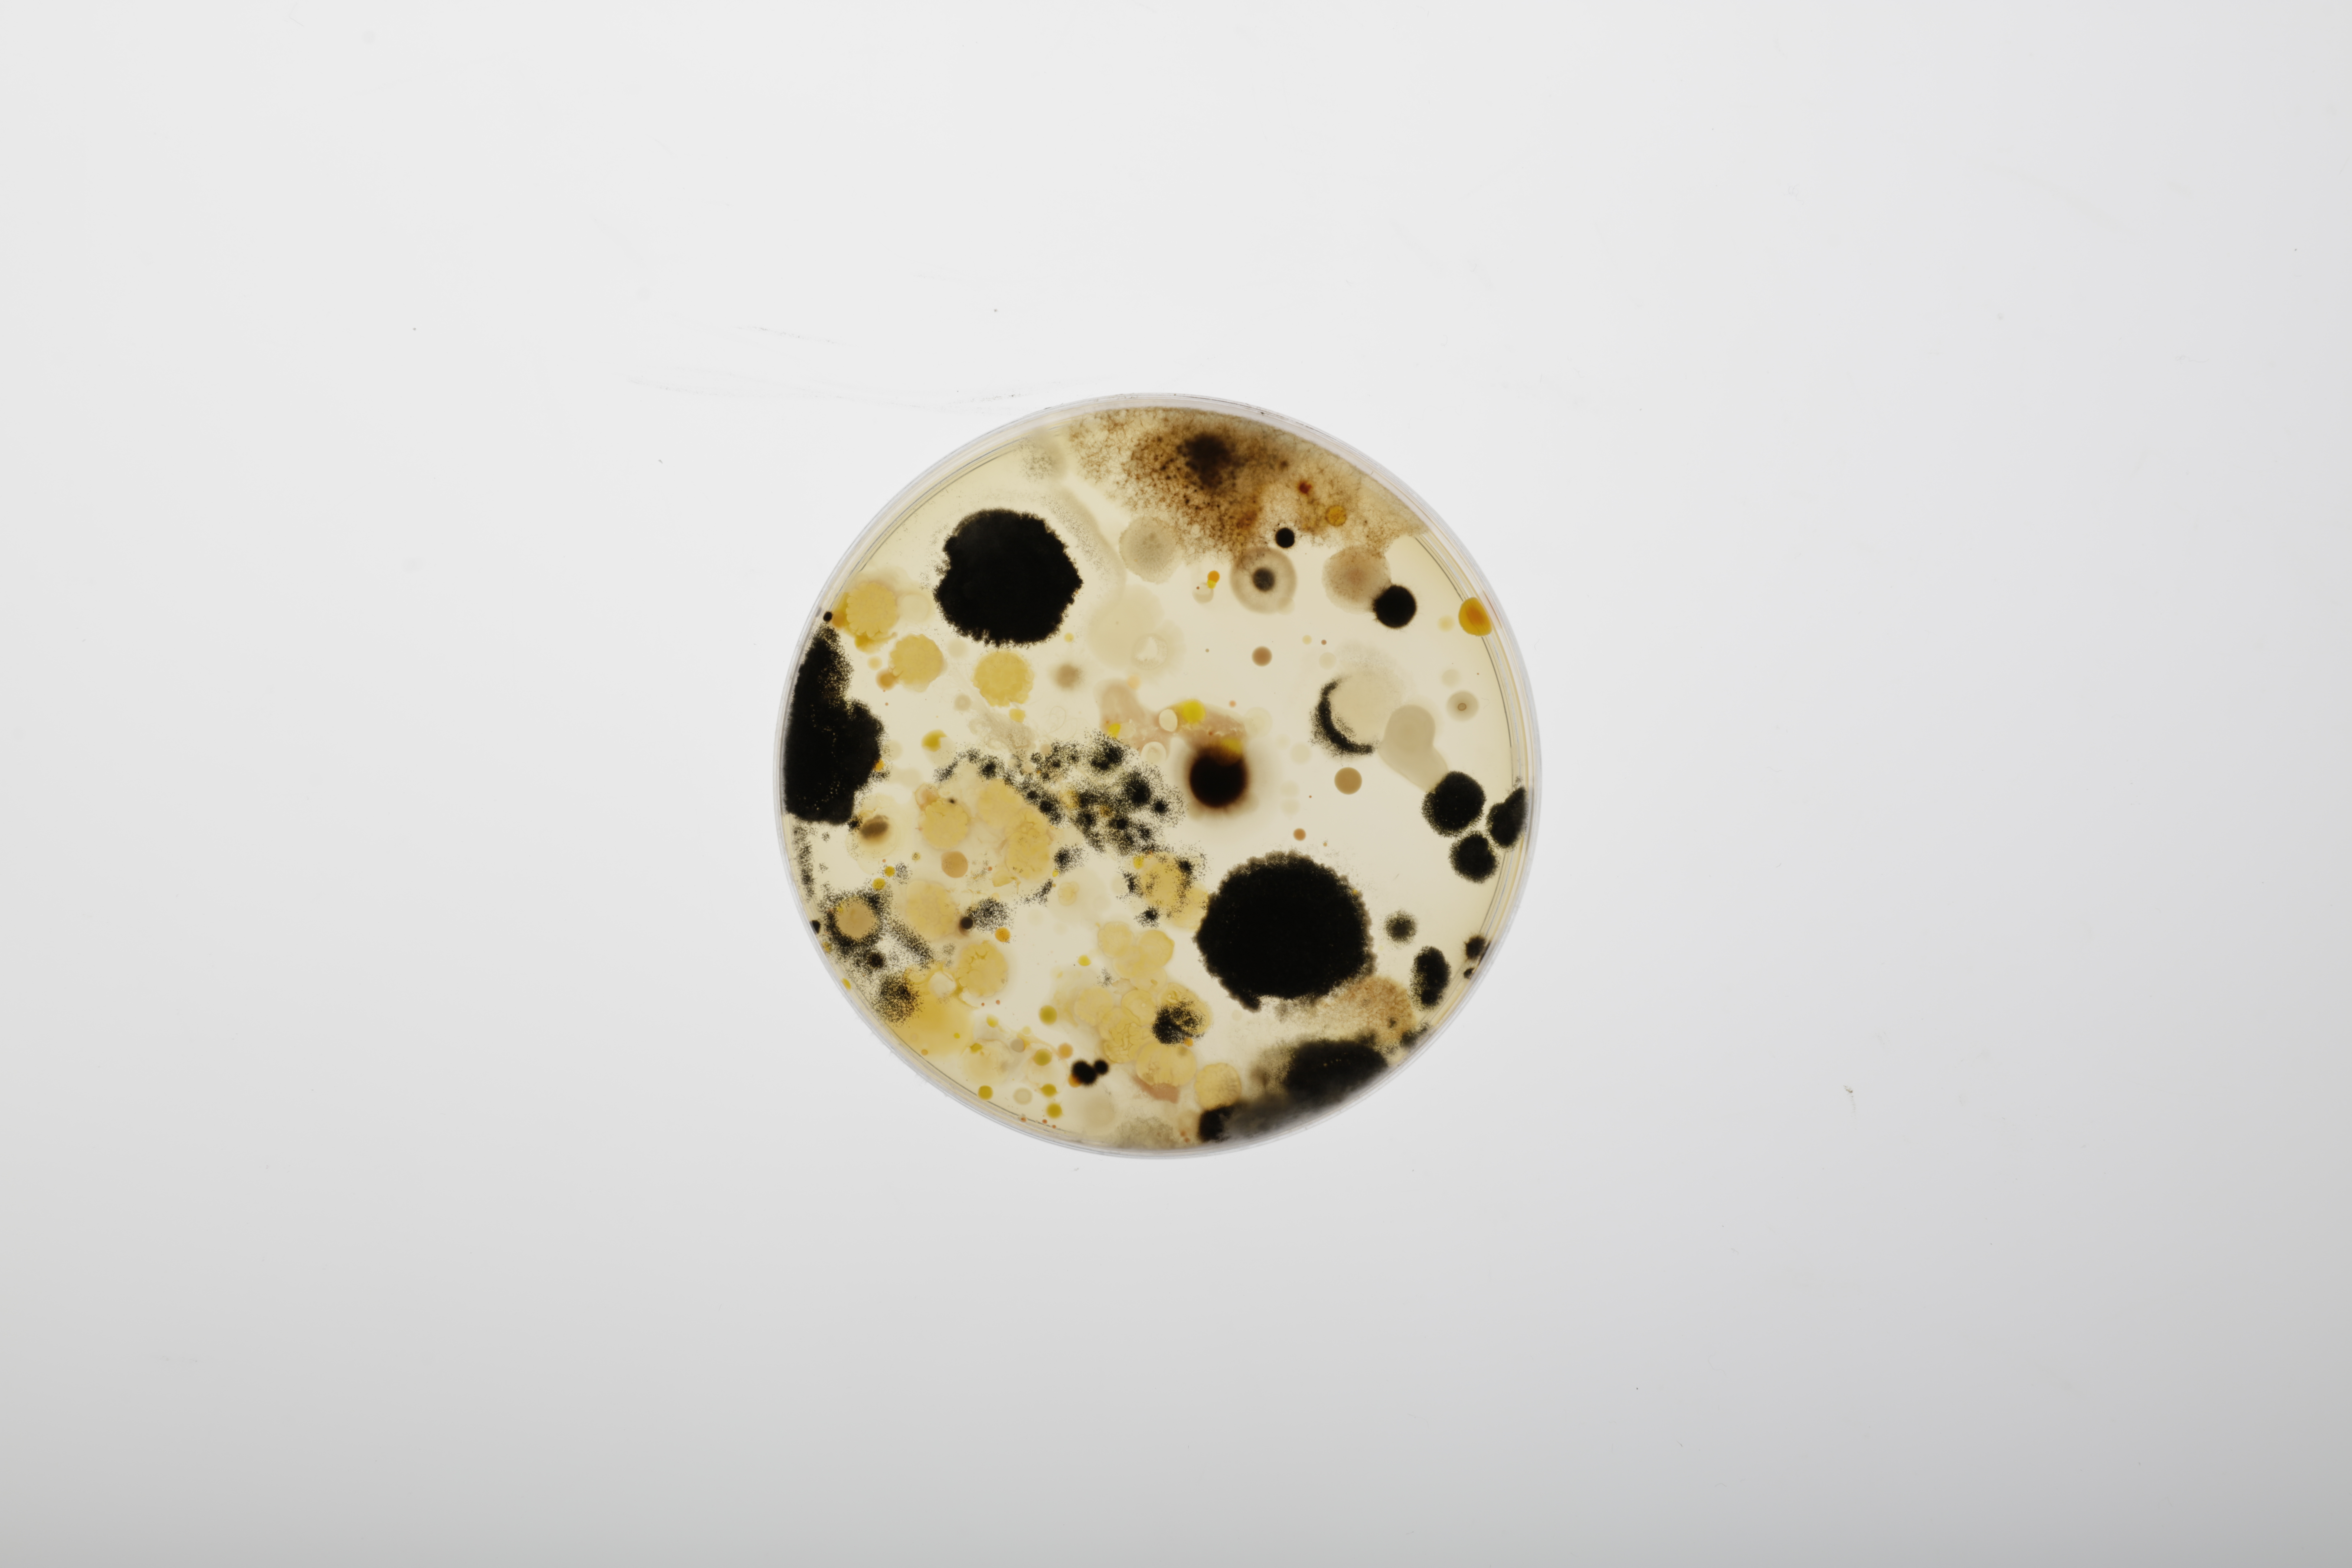

Bente Anna Koelink
"Swiss Stillness - Framing the Unseen Neutrality"
Section MS10, Freya Spencer-Wood
Keywords: nature, landscape, set design
Swiss Serenity: Revealing Unseen Neutrality is an investigative foray into the nuanced intersection of nature and politics, this project delves into the microbial tapestry thriving beneath the surface of geopolitical divides. While the concept of Switzerland’s political neutrality commonly evokes images of human diplomats and international organizations, this project aims to emphasize the significance of non-human species and natural elements in shaping the country’s ecological landscape. Emphasizing the interconnectedness of artificial and natural borders, it aims to spotlight Switzerland’s consistent neutral stance in both political and natural spheres. Shifting the focus away from political delineations, the endeavour aims to explore the ecological intricacies surrounding Switzerland’s borders with France and Germany. Venturing across the borderlines of Germany, France, and Switzerland in Basel, the collected soil samples and swabs unravel the hidden world of micro bacteria. As these invisible inhabitants reveal themselves, this study seeks to illuminate the striking parallels—or lack thereof—between the natural boundaries defined by the Rhine River and the human-drawn lines etched on maps. By analyzing the microbial footprints, it aims to provoke contemplation on the subtle complexities that blur the distinctions between political demarcations and the innate unity of ecosystems, questioning the tangible impact of man-made borders on the invisible realm beneath our feet.